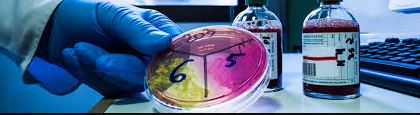

Da oltre trentanni, il Laboratorio Biotest rappresenta un punto di riferimento per la diagnostica clinica ad Adrano e in tutto il territorio circostante. Una realtà nata dallimpegno e dalla visione della famiglia Maria, che trova nella dedizione e competenza della Dott.ssa Maria Federica la sua guida attuale: una professionista che ha saputo coniugare passione, umanità e rigore scientifico per costruire una struttura solida, moderna e in continua evoluzione.
Al centro di ogni attività cè la persona, non solo il paziente. Ogni esame, ogni consulenza, ogni gesto nasce dallascolto attento delle esigenze individuali e da un profondo rispetto per chi sceglie Biotest per la propria salute.
Il laboratorio è dotato di tecnologie diagnostiche davanguardia, capaci di eseguire anche gli esami specialistici più avanzati con precisione e affidabilità. Tutto questo è reso possibile da un team di professionisti altamente qualificati e da un sistema di qualità certificata in costante aggiornamento.
Il Biotest opera in convenzione con il Sistema Sanitario Nazionale, garantendo accessibilità e trasparenza. Inoltre, per chi ha difficoltà a spostarsi, è disponibile su richiesta un servizio di prelievi a domicilio: un gesto che nasce dalla volontà di esserci, sempre, nel modo più umano possibile.
Dallaccoglienza al ritiro dei referti, la Dott.ssa Maria Federica e tutto il suo staff sono al fianco del paziente con professionalità, empatia e disponibilità, perché la salute è una cosa seria ma anche profondamente personale.